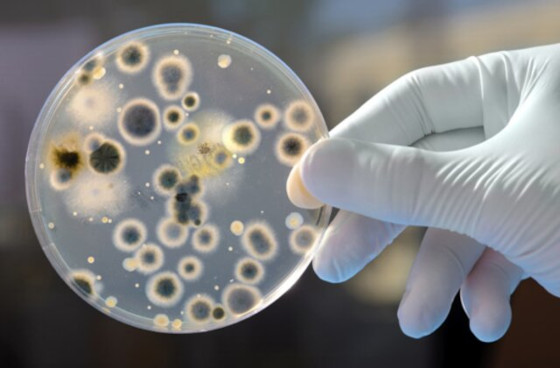

La légende du vaccin (2). Le verdict de l’Histoire sur la faillite des vaccins
par Jean-Yves Jézéquel
Lisez la première partie de cet article
Les chiffres des statistiques officielles accessibles depuis de longues années le prouvent, les courbes le montrent : les vaccins n’ont pas éradiqué les épidémies. Bien au contraire, ils ont favorisé l’émergence de maladies nouvelles devenues plus redoutables puisqu’elles surviennent sur des sujets adultes au système immunitaire affaibli par les vaccins.
 Ce que l’Histoire démontre opiniâtrement, c’est que les épidémies qui ont ravagé nos pays ont disparu sans aucun vaccin ! Il est clair que les partisans des vaccins ignorent cette réalité et on peut se demander pour quelle raison ? Pourquoi s’acharner à ne pas vouloir savoir ? Disons-le une fois de plus : ce comportement relève de la psychopathologie et des systèmes de conditionnement de l’être humain.
Ce que l’Histoire démontre opiniâtrement, c’est que les épidémies qui ont ravagé nos pays ont disparu sans aucun vaccin ! Il est clair que les partisans des vaccins ignorent cette réalité et on peut se demander pour quelle raison ? Pourquoi s’acharner à ne pas vouloir savoir ? Disons-le une fois de plus : ce comportement relève de la psychopathologie et des systèmes de conditionnement de l’être humain.
2.1 – La peste, le choléra et la lèpre
Ainsi, en 1347, la peste noire s’installait en Europe et en 1348 elle faisait périr la majorité de la population française. Pendant des siècles, elle fit des ravages à travers le monde pour s’éteindre et disparaître totalement sans aucune vaccination.
Le choléra allait, lui aussi, semer la terreur dans nos pays européens pour disparaître à son tour sans aucun vaccin.
Si la vaccination contre ces maladies avait existé et avait été obligatoire durant ces périodes critiques, il est certain que les propagandistes et les fanatiques du vaccin auraient attribué cette disparition à l’efficacité des vaccins.
L’étude rigoureuse des faits historiques, impute ces régressions à bien d’autres facteurs. La lèpre existe encore dans certains pays à l’état endémique, elle ne cause plus de ravages comme elle le fit par le passé, et les grandes épidémies ne sévissent plus. Faut-il préciser qu’il n’existe aucun vaccin contre cette maladie ?
Pour les historiens des vaccins, il suffit d’observer les courbes de déclin des maladies pour s’apercevoir que ce déclin a toujours commencé bien avant l’introduction des vaccins.
Pour attester de l’action bénéfique des vaccins, la médecine allopathique se base sur le taux d’anticorps obtenu après une injection. Certes, tout antigène introduit dans l’organisme produit une réaction. La plupart du temps, le système immunitaire exprime cette réaction par la production d’anticorps, mais leur présence ne prouve pas qu’ils vont immuniser l’individu. Leur augmentation signifie surtout un affolement des défenses immunitaires.
Dans bien des cas, les vaccins fortifient la maladie et sont « facilitants ». Les mécanismes engagés dans le corps se trouvent souvent débordés, provoquant des combinaisons anticorps/antigène, appelées « complexes immuns » ; ces combinaisons restent en circulation dans l’organisme, provoquant des maladies graves. Quant à la durée de vie produite par un antigène vaccinal, elle est considérablement plus courte que celle des anticorps naturels.
La vaccination met en jeu des mécanismes très différents de ceux qui sont activés par une intrusion virale naturelle.
Les vaccins sont des facilitateurs de l’émergence d’autres maladies, parce que le terrain immunitaire est affaibli. A cause de ce phénomène d’immunodéficience, provoqué par le vaccin, le terrain se laisse plus facilement assaillir par des germes qui prolifèrent et deviennent virulents.
Mirko D. Grmek, professeur d’histoire de la médecine à l’Ecole des hautes études, donne au phénomène émergent d’une maladie qui disparaît ensuite d’elle-même, le nom de « pathocénose ».
La « pathocénose » explique l’apparition et la disparition naturelles d’une épidémie.
« Ainsi, la vaccination antivariolique a rendu plus virulent le bacille de Koch, ce qui explique le fléau de la tuberculose au XIXe siècle. La vaccination contre la diphtérie couplée avec la vaccination anti-coqueluche a rendu virulent le virus de la polio, aussi a-t-on eu des pics épidémiques quelques années après la vaccination systématique contre la diphtérie. Le vaccin contre la polio accompagné du cocktail prévu par le calendrier vaccinal a contribué à l’effondrement du système immunitaire et à l’installation d’un syndrome d’immunodéficience acquise. » (Cf., Sylvie Simon, paru dans le magazine Nexus, mars-avril 2013, n°85)
2.2 – Narcolepsie, Alzheimer, maladie de Guillain-Barré, cancers, myofasciites à macrophages, syndrome des antiphospholipides…….
Les vaccins comme les antibiotiques diminuent la résistance naturelle du terrain, transformant ce terrain en y favorisant la cancérisation. Habituellement, les médecins convaincus de « l’évidence des bienfaits du vaccin » considèrent qu’un enfant vacciné ne développant pas telle ou telle maladie est donc « immunisé », alors que la réalité est bien différente : il est nettement plus juste de dire qu’il n’a plus la force de réagir. Les maladies chroniques s’installent chez ceux qui ont un niveau d’énergie, trop bas. Ils ne font pas de réactions fortes parce que l’organisme est affaibli de l’intérieur.
Les vaccins comme les antibiotiques diminuent la résistance naturelle du terrain, transformant ce terrain en y favorisant la cancérisation. Habituellement, les médecins convaincus de « l’évidence des bienfaits du vaccin » considèrent qu’un enfant vacciné ne développant pas telle ou telle maladie est donc « immunisé », alors que la réalité est bien différente : il est nettement plus juste de dire qu’il n’a plus la force de réagir. Les maladies chroniques s’installent chez ceux qui ont un niveau d’énergie, trop bas. Ils ne font pas de réactions fortes parce que l’organisme est affaibli de l’intérieur.
Harris Coulter, un spécialiste américain de l’histoire des vaccinations, dans son livre « Vaccination, social violence and criminality », dit que toute vaccination est susceptible de provoquer une encéphalite légère ou grave. Ce phénomène provoque une détérioration des gaines de myéline dans le cerveau. Ces transformations pathologiques conduisent à des handicaps divers comme les problèmes de comportement.
Aux USA, un enfant sur cinq a subi des atteintes cérébrales. Des chercheurs ont découvert une similitude entre certains virus et la structure de la myéline. Cette découverte capitale explique pourquoi nombre de maladies auto-immunes apparaissent après la vaccination : le corps ne reconnaît plus l’antigène à combattre et s’attaque à ses propres cellules, entraînant des maladies très invalidantes sur le long terme.
Les spécialistes en immunologies s’interrogent actuellement sur les poussées épidémiques qui surviennent spécifiquement dans les populations vaccinées ! Ils parlent alors d’une « faillite de la vaccination », qui non seulement présente des effets pervers mais qui de plus, n’a jamais « éradiqué » une maladie.
Non seulement les vaccins contiennent des produits toxiques connus qui peuvent provoquer des dégâts neurologiques, mais il faut également souligner que les fabricants ne réalisent pas les mêmes études de sécurité pour les vaccins comme ils le font (pas toujours !) pour les autres médicaments.
Depuis l’affaire des effets secondaires désastreux observés à la suite des « vaccins anti-covid-19 », un nombre alarmant d’études scientifiques a mis en lumière les dangers des vaccins en général.
Il ne s’agit pas d’alertes provenant des milieux dits « complotistes », mais de la communauté médicale internationale elle-même qui exprime ses doutes sérieux sur l’opportunité des vaccins.
Le British Medical Journal, publiait le 30 janvier 2013 une étude démontrant que le vaccin contre la grippe H1N1 : Pandermix, avait causé des milliers de cas de narcolepsie chez les enfants, une maladie grave et incurable, sans que la règle bénéfice/risque ne soit venue approuver l’utilité du vaccin. Une association a également été repérée entre le vaccin contre la grippe et la maladie de Guillain-Barré.
Le Gardasil, vaccin contre le papillomavirus et le cancer du col de l’utérus, est pointé par l’association Sanevax, car ce vaccin est relié à 29.003 effets secondaires graves et au moins à 130 décès connus.
Les historiens des vaccins savent aujourd’hui que le vaccin contre l’hépatite B, tue des cellules du foie, alors qu’il a été conçu pour protéger contre une maladie du foie. Le 21 novembre 2012, le Conseil d’Etat français a reconnu que l’aluminium dans le vaccin contre l’hépatite B, avait été la cause d’une terrible maladie invalidante, la myofasciite à macrophages, dont souffrent des milliers de personnes qui ont été vaccinées contre l’hépatite B.
Les vaccins peuvent en effet contenir diverses substances notoirement toxiques, même à faibles doses, comme le formaldéhyde (cancérigène), le mercure (neurotoxique), l’aluminium (neurotoxique) ou le phénoxyéthanol et aujourd’hui, au sujet du vaccin anti-covid, l’oxyde de graphène. On imagine les effets que peuvent avoir ces substances sur des enfants en pleine croissance.
Ces molécules sont des adjuvants destinés à stabiliser les vaccins ou à renforcer leur efficacité en stimulant la réponse immunitaire. Ainsi les personnes prédisposées génétiquement peuvent voir leur immunité s’emballer et déclencher alors une maladie auto-immune, comme la fameuse myofasciite à macrophages, le syndrome de Guillain-Barré ou le syndrome des antiphospholipides, des effets secondaires rares et graves mais parfaitement connus.
Le lien a été établi aujourd’hui entre l’aluminium des vaccins et la maladie d’Alzheimer, mais aussi du cancer du sein, la maladie d’Alzheimer étant une nouvelle maladie apparue après-guerre et suite aux campagnes de vaccinations.
Ces effets indésirables sont, bien entendu, présentés par les « autorités médicales » et la grande presse aux ordres du système, comme mineurs au regard des bénéfices obtenus par les vaccins.
3 – Le cas particulier de l’autisme
 L’autisme se manifeste en général au cours des trois premières années, période pendant laquelle les enfants subissent de nombreuses vaccinations. Les cas d’autisme se sont multipliés depuis une trentaine d’années. Après la généralisation du vaccin diphtérie-Tétanos-coqueluche et l’arrivée du vaccin contre la rougeole, les consultations pour des cas d’autisme ont explosé, et elles ont décuplé avec l’introduction du ROR et du vaccin anti-hépatite B. On peut présumer d’une large prolifération de l’autisme avec les 11 vaccins devenus obligatoires sous Macron et sa ministre de la santé réputée avoir été la plus grande représentante historique des laboratoires : Agnès Buzyn, aujourd’hui passant sa vie devant les tribunaux.
L’autisme se manifeste en général au cours des trois premières années, période pendant laquelle les enfants subissent de nombreuses vaccinations. Les cas d’autisme se sont multipliés depuis une trentaine d’années. Après la généralisation du vaccin diphtérie-Tétanos-coqueluche et l’arrivée du vaccin contre la rougeole, les consultations pour des cas d’autisme ont explosé, et elles ont décuplé avec l’introduction du ROR et du vaccin anti-hépatite B. On peut présumer d’une large prolifération de l’autisme avec les 11 vaccins devenus obligatoires sous Macron et sa ministre de la santé réputée avoir été la plus grande représentante historique des laboratoires : Agnès Buzyn, aujourd’hui passant sa vie devant les tribunaux.
Comment se fait-il qu’on n’ait pas cherché à approfondir les études sur ces coïncidences temporelles ? Comment se fait-il que les pouvoirs discréditent toute étude sérieuse mettant en cause la toxicité des vaccins alors qu’ils tiennent compte et plébiscitent certaines études simplistes et non rigoureuses pour les promouvoir ? Pourquoi les accidents relèvent-ils toujours de coïncidences ?
En fin 1990, les sels d’aluminium sont déclarés, par les chercheurs du monde entier, responsables des autismes, de la sclérose en plaques, de la myofasciite à macrophages, cette dernière maladie ayant été signalée pour la première fois en 1998. Le professeur Romain Gherardi publiait les résultats de ses recherches en 2016 : « Site NIH de la National Library of Medicine, 28 novembre 2016 ». Le professeur confirmera encore la conclusion de ses recherches en avril 2001 dans le mensuel « Alternative Santé l’Impatient » : « sur 50 malades, 85% d’entre eux avaient reçu le vaccin de l’hépatite B et 15% des autres restants avaient reçu récemment le vaccin anti-tétanos ». L’ANSM (Agence Nationale de Sécurité du Médicament) niait le rapport qui existe et qui a été démontré entre l’injection contenant de l’aluminium et les troubles graves étudiés par le professeur Gherardi.
Les conséquences dramatiques de ces vaccinations allaient opposer les experts devant les tribunaux. L’Etat reconnaissait enfin sa responsabilité. Un arrêt du Conseil d’Etat de mars 2007, allait permettre l’indemnisation de 150 victimes des vaccins. Le nombre peu élevé de contaminés aujourd’hui ne justifiant pas la vaccination de masse.
L’opinion publique manipulée, attribue toujours un mérite inexistant aux vaccins qui nous protégeraient de nombreuses maladies infectieuses et pensent encore à ce jour qu’ils ont éradiqué toutes les épidémies décimant autrefois nos pays : le typhus, la diphtérie, la coqueluche, la scarlatine, la tuberculose, la méningite, le tétanos et, bien entendu, les maladies infantiles, la rougeole, les oreillons, la rubéole, etc.
4 – Selon les documents historiques, la vaccination est bien une fiction
Se reporter au dossier « Survey on Vaccinations in Europe » dont sont tirés les chiffres suivants.
La vérité scientifique et historique démontre qu’il s’agit d’une pure fiction.
Toutes ces maladies que l’on vient d’évoquer avaient cessé de faire des morts à grande échelle bien avant que l’on introduise les vaccins. Disons-le et répétons-le : c’est l’amélioration des conditions de vie, de l’hygiène, de l’eau potable, le recul de la malnutrition et du paupérisme qui expliquent la disparition de ces maladies.
4.1 – La Diphtérie
 Dans le début des années 1900, en Espagne, il y avait encore 5.000 morts par an de diphtérie. Puis ce chiffre est tombé à 81 en 1964, l’année où la vaccination obligatoire fut introduite.
Dans le début des années 1900, en Espagne, il y avait encore 5.000 morts par an de diphtérie. Puis ce chiffre est tombé à 81 en 1964, l’année où la vaccination obligatoire fut introduite.
En France, la vaccination obligatoire contre la diphtérie fut imposée en 1938. L’année suivante, il y eut 15.000 cas de diphtérie puis trois fois plus pendant la guerre !
En Allemagne, il y avait 100.000 cas de diphtérie par an au cours de la Première Guerre mondiale. Les nazis imposèrent le vaccin obligatoire contre la diphtérie en 1939. En 1940, il y avait à nouveau 100.000 cas, puis 250.000 en 1945. Ce qui démontre que ce sont les conditions de vie, les situations d’hygiène, de nutrition, qui expliquent les épidémies……. Après la guerre, la vaccination obligatoire fut abandonnée et le nombre de malades de la diphtérie passa à 800 en 1972. Les cas sont rares aujourd’hui, mais repartent à la hausse dans les milieux défavorisés des réfugiés sans logis et autres victimes du désastre économique actuel malgré les vaccins…….
Tous les chiffres répertoriés par les historiens indiquent que la diphtérie se répand lorsque les conditions de vie se dégradent (crise économique, chômage endémique, existence sous le seuil de pauvreté, guerre), et que les campagnes de vaccination sont impuissantes à enrayer ce phénomène.
L’Histoire souligne que chaque retour à la prospérité et à une meilleure hygiène de vie s’accompagne d’un recul des maladies, jusqu’à leur disparition complète.
Le scandale dans tout cela, c’est que des gouvernements imposent la vaccination systématique de la population pour des maladies devenues inexistantes : c’était le cas de l’Espagne en 1964 et de l’Allemagne en 1939.
Les mêmes phénomènes ont été observés avec les autres grandes maladies infectieuses.
Les traitements sérieux reposent sur le chlorure de magnésium dont on connaît l’efficacité dans les états infectieux (diphtérie, tétanos, polio) grâce aux travaux du Dr Neveu, élève du Pr Delbet. Le Dr Neveu avait rédigé un rapport sur les guérisons qu’il avait obtenues chez des personnes atteintes de diphtérie. Le Pr. Delbet voulut présenter ce rapport à l’Académie de Médecine. Mais le réflexe sectaire du corps médical, toujours enfermé dans sa croyance fétichiste du vaccinalisme, refusa de remettre en cause le dogme de l’infaillibilité vaccinale.
Dans une lettre au Dr Neveu, en date du 16 novembre 1944, il écrivait : « La publication de ma communication du 20 juin est définitivement refusée. Le Conseil de l’Académie a trouvé après 6 mois de réflexion, l’argument suivant : en faisant connaître un nouveau traitement de la diphtérie, on empêcherait les vaccinations et l’intérêt général est de généraliser ces vaccinations. »
Voilà un exemple flagrant de mensonge par omission : les chercheurs indépendants qui trouvent des solutions efficaces et peu coûteuses, mais qui s’écartent du narratif mensonger officiel, sont condamnés au silence. Il ressort de ce rapport que l’Académie de Médecine a décidé délibérément d’étouffer un traitement qui aurait pu sauver des milliers de vie, mais qui aurait risqué de concurrencer les vaccins. Voilà qui donne une idée des puissants intérêts qui dictent la conduite de tout ce qui représente l’autorité sanitaire du pays. On peut tout à fait parler de pratiques criminelles des autorités sanitaires, en toute impunité. Les braves gens peuvent crever, cela laisse indifférent les responsables, car la loi de l’argent, des intérêts, des profits dépassent de loin la vie des personnes considérées comme des « inutiles », des « substituables », « ceux qui ne sont rien »…….
4.2 – La Typhoïde, la Coqueluche et la Scarlatine
 La fièvre typhoïde, qui décimait les armées de Napoléon et fit 5.000 à 7.000 morts par an pendant la Guerre civile espagnole, à partir de 1937, fut quasiment éradiquée à la fin des années 50, sans qu’il y ait eu de campagne de vaccinations.
La fièvre typhoïde, qui décimait les armées de Napoléon et fit 5.000 à 7.000 morts par an pendant la Guerre civile espagnole, à partir de 1937, fut quasiment éradiquée à la fin des années 50, sans qu’il y ait eu de campagne de vaccinations.
Le vaccin contre la coqueluche ne commença à être administré que dans les années 40 aux Etats-Unis. En 1953, il fut autorisé en Angleterre. A ce moment-là, la coqueluche faisait 25 morts par million d’enfants de moins de 15 ans, contre 1.500 en 1850. Une baisse de 98,5 % sans que le vaccin y soit pour quoi que ce soit.
En Espagne, la coqueluche ne faisait plus que 33 morts par an en 1965 quand furent lancées les campagnes de vaccination DPT (diphtérie, coqueluche, tétanos).
La scarlatine ne fait pratiquement plus aucun mort depuis les années 60 bien qu’il n’y ait jamais eu de vaccin.
4.3 – ROR
En France, les campagnes à grande échelle de vaccination ROR (rougeole, oreillons, rubéole) furent lancées en 1983, alors que le nombre de décès causés par la rougeole était tombé à 20 personnes par an, contre 3.756 en 1906, une baisse de la mortalité de 99,5 % sans vaccin ! En Espagne, 18.473 personnes moururent de la rougeole en 1901, contre 19 en 1981. Les campagnes de vaccination nationales commencèrent pourtant en 1982 !
Pouvoirs publics, médecins, et médias persistent à répéter la même rengaine : « Le vaccin reste la meilleure protection contre la maladie et cette maladie est fréquente et parfois mortelle », alors que c’est foncièrement faux : les rougeoles sont rarissimes et parfaitement bénignes en Europe, dans les familles qui nourrissent correctement leur enfant.
Les mensonges dénoncés ici concernent le monde entier. Ainsi, lorsque débutèrent les premières vaccinations ROR au Japon, le Ministère de la santé signala les effets indésirables dans un cas sur 200.000. Quelques années plus tard, ayant « révisé » les chiffres, le même ministère annonçait un accident pour 3.000 vaccinés. Les statistiques ayant été à nouveau « révisées », il fut reconnu un accident pour 1.300 vaccinés, chiffre étrangement différent de ceux précédemment publiés.
Mais en France, nous n’avons aucun problème avec le ROR et l’on continue à administrer ce vaccin en l’exigeant même pour l’admission en crèche. Dans le domaine du mensonge, nos « experts » restent les champions du monde ! « Quand demandera-t-on des comptes à ces responsables de la santé publique en rappelant leurs irresponsabilités », demande le Professeur Jacques Testart, biologiste réputé ?
Lisez la troisième partie de cet article
yogaesoteric
5 juillet 2023
